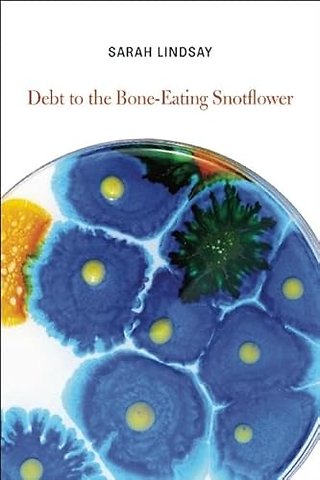

Sarah Lindsay
Copper Canyon Press,U.S.
e druk, 2014
9781556594465
Debt to the Bone-Eating Snotflower
Specificaties
Paperback, 88 blz.
|
EN
Copper Canyon Press,U.S. |
e druk, 2014
ISBN13: 9781556594465
Rubricering
Levertijd ongeveer 15 werkdagen